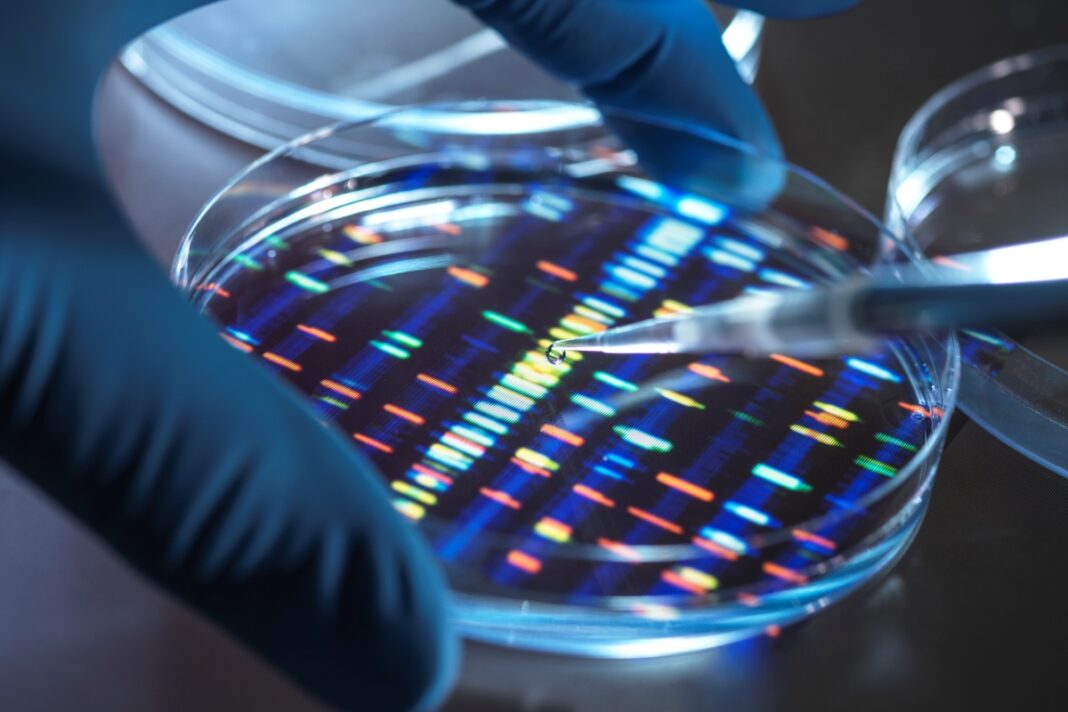

Cientistas desenvolveram uma terapia genética capaz de corrigir, em camundongos, uma mutação rara que compromete vasos sanguíneos e causa morte precoce. A condição, chamada síndrome de disfunção do músculo liso multissistêmica (SDMLM), aparece na infância e coloca em risco a vida de bebês e crianças pequenas. O estudo foi publicado na revista Nature Biomedical Engineering nesta quinta-feira (11/9).
A síndrome é causada por uma mutação no gene ACTA2, identificada como R179H. Essa alteração impede o funcionamento correto das células musculares lisas, responsáveis por dar sustentação às artérias. Como resultado, as crianças afetadas podem desenvolver aneurismas, acidentes vasculares cerebrais (AVCs) e dissecção da aorta muito cedo — em alguns casos, nos primeiros anos de vida.
Para enfrentar o problema, a equipe de pesquisadores criou uma ferramenta de edição genética personalizada: um editor do tipo CRISPR–Cas9, ajustado para corrigir exatamente a mutação — trocando uma única “letra” do DNA, sem cortar a dupla hélice. Esse desenho foi feito para reduzir ao máximo alterações indesejadas em outras regiões do genoma.
O próximo passo foi entregar essa enzima ao organismo. Para isso, os cientistas usaram um vetor viral AAV, direcionado especificamente às células musculares lisas dos vasos sanguíneos. Em camundongos portadores da mutação, a terapia corrigiu a falha genética em diferentes tecidos, incluindo a aorta e os vasos cerebrais, melhorando os sinais da doença e aumentando a sobrevida dos animais.
Segundo os autores, a abordagem também se mostrou relativamente segura: houve baixa incidência de edições fora do alvo e nenhum efeito adverso grave identificado nos testes com animais. Apesar disso, eles reforçam que o tratamento ainda precisa passar por estudos de longo prazo para verificar riscos de resposta imunológica ao vírus ou falhas na estabilidade da correção genética.
O impacto potencial é grande. Como a síndrome começa cedo e muitas vezes se manifesta em bebês, a terapia traz esperança de, no futuro, oferecer uma opção real de tratamento para famílias que hoje não têm alternativa. A equipe já iniciou conversas com autoridades regulatórias para avaliar caminhos até ensaios clínicos em humanos.
Siga a editoria de Saúde e Ciência no Instagram e fique por dentro de tudo sobre o assunto!